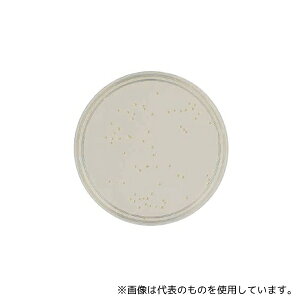
xNgEfBbL\ 252479 BD BBL(TM) SCDV|n RT 1(1{×100)
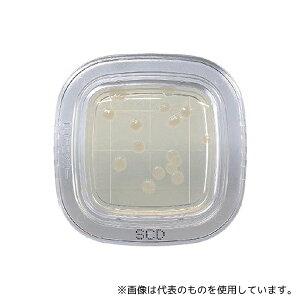
hw ؂`FbN?DD SCDV|n 1(20) PD0023 1(20)

「SCD」の人気商品一覧 | 安い商品を通販サイトから探す
1,949件 41〜80件を表示- 価格の安い順
- 価格の高い順
- 検索条件:
- 計測用具
- 本ページでは掲載するECサイトやメーカー等から購入実績などに基づいて手数料を受領しています。

その他の計測用具
【アズワン AS ONE】分析・特殊機器 検査用品 微生物検査機器 ●無菌試験専用の液体培地です。 ●キャップ形状はシリンジ挿入用にセプタムキャップになっています。 ●輸送時における破損防止のため、保護材でボトル上下が固定されていま

その他の計測用具
【アズワン AS ONE】分析・特殊機器 分離・分析ロシ 分析機器その他 ●日本薬局方の微生物限度試験など用で、常温保存で6か月の有効期限です。 商品の仕様 ●生培地 ●3局対応 ●入数:100枚入 ●JANコード:382902524...
この商品で絞り込む

その他の計測用具
【アズワン AS ONE】分析・特殊機器 分離・分析ロシ 分析機器その他 ●日本薬局方準拠培地 ●一般細菌用 商品の仕様 ●内容量:300g ●重量:438g ●※保存方法:室温・防湿 ●※有効期限:製造より3年 ●JANコード:49...
この商品で絞り込む

測量用品
・携帯に便利なカードサイズの水平器! カラークリア 本体サイズ(cm)幅8.6×奥行5.5×高さ54 全長86mm 特徴これ1つで、いろいろな角度、勾配が測定可能です 用途水平、勾配、0〜45°測定に 商品説明カードサイズなので携帯に...
この商品で絞り込む

直尺・曲尺
【商品説明】●1分単位の目盛が見やすい階段状目盛です。●尺相当目は、連続追数字です。●直角が狂いにくい角厚タイプです。●高所作業に最適なセーフティーロープ取付穴付です。●直角測定に適した両面尺目盛です。●表面と裏面の目
この商品で絞り込む

その他の計測用具
【アズワン AS ONE】分析・特殊機器 分離・分析ロシ 分析機器その他 ●日本薬局方準拠培地 ●一般細菌用 商品の仕様 ●内容量:300g ●重量:409g ●※保存方法:室温・防湿 ●※有効期限:製造より12ヵ月 ●JANコード:...
この商品で絞り込む

測量用品
《仕様》 ●呼び寸法:1尺 ●タイプ:両同目角厚 ●長手:340mm ●妻手:165mm ●巾:15mm ●厚さ:1.3mm ●表目盛:長手 1尺、妻手 5寸 ●裏目盛:長手 1尺、妻手 5寸 ●精度:
この商品で絞り込む

その他の計測用具
【アズワン AS ONE】分析・特殊機器 分離・分析ロシ 分析機器その他 ●日本薬局方準拠培地 ●一般細菌用 商品の仕様 ●内容量:300g ●重量:438g ●※保存方法:室温・防湿 ●※有効期限:製造より3年 ●JANコード:49...
この商品で絞り込む

その他の計測用具
【アズワン AS ONE】分析・特殊機器 分離・分析ロシ 分析機器その他 ●日本薬局方準拠培地 ●一般細菌用 商品の仕様 ●内容量:300g ●重量:409g ●※保存方法:室温・防湿 ●※有効期限:製造より12ヵ月 ●JANコード:...
この商品で絞り込む

その他の計測用具
用途:一般細菌用日本薬局方準拠培地 入数:内容量:300g製品サイズ:9cm*9cm*19cm 保存方法:室温防湿使用期限:製造より3年 重量:438g ※事業者向け商品です。ご使用後の培地類は、速やかにオートクレーブ滅菌後、地方自治...
この商品で絞り込む

その他の計測用具
●日本製。●カードサイズで薄型なので携帯に便利です。●いろいろの勾配や角度の測定が出来ます。●水平・垂直・45°が測定出来ます。●勾配の測定●長さ(mm):86●高さ(mm):54●厚さ(mm):5.5●最小表示:1度●カード型角度測...
この商品で絞り込む

その他の計測用具
【アズワン AS ONE】分析・特殊機器 分離・分析ロシ 分析機器その他 ●日本薬局方準拠培地 ●一般細菌用 商品の仕様 ●入数:100枚 ●重量:4000g ●※保存方法:2〜25℃(常温) ●有効期限:製造後6ヶ月 ●★1枚あたり...
この商品で絞り込む
その他の計測用具
【アズワン AS ONE】分析・特殊機器 分離・分析ロシ 分析機器その他 ●日本薬局方の微生物限度試験など用で、中和剤としてレシチン、ポリソルベートが含有されてます。 商品の仕様 ●生培地 ●3局対応 ●入数:100枚入 ●JANコー...
この商品で絞り込む

その他の計測用具
【アズワン AS ONE】分析・特殊機器 検査用品 微生物検査用品 ●培地は面積10cm2の専用シャーレに盛り上がった状態で凝固されています。 ●培地を検体表面に直接押しつけることで検体採取することができます。 商品の仕様 ●生菌数用...
この商品で絞り込む

その他の計測用具
《仕様》●呼び寸法:1尺●タイプ:両同目角厚●長手:340mm●妻手:165mm●巾:15mm●厚さ:1.3mm●表目盛:長手 1尺、妻手 5寸●裏目盛:長手 1尺、妻手 5寸●精度:目盛側面の直角度 100mmにつき0.1mm以下、...
この商品で絞り込む

墨つぼ・チョーク・マーカー
特徴いろいろな角度・勾配を測れます。見やすい角度目盛り。カードサイズなので携帯に便利です。仕様カラー:ホワイト×グリーンサイズ(mm):5.5×54×86重量:23g体水平・勾配・0〜45°測定可能材質:アクリル樹脂気泡管感度:1.0...
この商品で絞り込む

その他の計測用具
●ステンレス筐体が静電気の影響を抑えます。●最大2段まで段積みが可能です(SCD-2H同士の2段積みはできません)。●本体背面に静電気対策用アース端子付きです。●静電気対策に優れた小型デシケーター。●材質:本体...
この商品で絞り込む

その他の計測用具
●スティッククリーナーとアタッチメントをコンパクトに収納できる、別売品スタンドです。●付属のアタッチメントが充電スタンドに収納できるので、邪魔にならずなくす心配がありません。●スタンドにクリーナーを設置し静電モップを
この商品で絞り込む

その他の計測用具
≪特徴≫ ★いろいろな角度・勾配を測れます。 ★便利な目盛付きです。 ★カードサイズなので携帯に便利です。 ●本体仕様 ・水平・勾配・0〜45°測定可能 ・アクリル樹脂 ●サイズ:5.5×54×86(mm) ●カラー:グリーン・レッド...
この商品で絞り込む

その他の計測用具
《仕様》●呼び寸法:1尺●タイプ:両同目角厚●長手:340mm●妻手:165mm●巾:15mm●厚さ:1.3mm●表目盛:長手 1尺、妻手 5寸●裏目盛:長手 1尺、妻手 5寸●精度:目盛側面の直角度 100mmにつき0.1mm以下、...
この商品で絞り込む
その他の計測用具
【アズワン AS ONE】分析・特殊機器 培養機器・容器 培地等 ●ぺたんと押して微生物チェックします。 ●特定の汚染菌の有無を選択的に確認できます。 ●一般細菌検出用培地は最短8時間で判定が可能です(発色液を使用)。 商品の仕様 ●...
この商品で絞り込む

温湿度計
【アズワン AS ONE】物理・物性測定器 温度・湿度管理機器 温度・湿度管理関連機器 商品の仕様 ●入出力点数:入力8点/出力4点 【※ご注意ください】商品は代表の画像を使用しています。

その他の計測用具
材質:本体・棚板/ステンレス(SUS304)、窓枠/ABS樹脂、観察窓/ガラス 仕様:ゴム足付き 外寸法:400×350×862mm 内寸法:381×325×790mm 重量:13kg 付属品:棚板×3枚、鍵×2個 ※シリカゲル皿は付...
この商品で絞り込む

その他の計測用具
【アズワン AS ONE】分析・特殊機器 分離・分析ロシ 分析機器その他 ●日本薬局方準拠培地 ●一般細菌用 商品の仕様 ●内容量:300g ●重量:438g ●※保存方法:室温・防湿 ●※有効期限:製造より3年 ●JANコード:49...
この商品で絞り込む

その他の計測用具
●操作はスイッチを入れ、温度を設定するだけで簡単●撹拌噴出流量が調整でき、方向も可変式なので、いろいろな水槽に対応できます●移送分岐管NP-2(別売)を使って、密閉容器への恒温水の循環ができます●安全装置として、水位低下時

その他の計測用具
スタンダードステンレス小型デシケーター 400×350×862mm (1台)
この商品で絞り込む

その他の計測用具
エビスダイヤモンド ED-SCD/ED-SCDR/ED-SCDBLエビスダイヤモンド全商品取り扱い中!!お探しはページ左上の商品検索窓で品番を入力!!

測量用品
気泡の中央で目盛を測定します いろいろな角度・勾配を測れます 見やすい角度目盛り カードサイズなので携帯に便利です
![■AS スタンダード小型デシケーターSCD-2H〔品番:2791002〕【1010488:0】[送料別途見積り][掲外取寄][店頭受取不可]](https://tshop.r10s.jp/hcvalor-eshop/cabinet/trusco/1010/trusco-1010488.jpg?fitin=300:300)
その他の計測用具
7910-02《特長》●ステンレス筐体が静電気の影響を抑えます。●最大2段まで段積みが可能です(SCD-2H同士の2段積みはできません)。●本体背面に静電気対策用アース端子付きです。《用途》●材質:本体

その他の計測用具
消耗品 金属・樹脂実験必需2 実験室必需用品、器具その他 ●SCD41を用いたCO2&温度&湿度センサー ●Sensirion社製のSCD41モジュールは、小型ながら温度、湿度、CO2を同時に測定できる多機能なセンサーです...
![アズワン AS ONE サニスペック粉末培地 SCD寒天・顆粒 4-1126-04 [1445-0082118]](https://tshop.r10s.jp/daishinshop/cabinet/item/1445-99/1445-0082118.jpg?fitin=300:300)
はかり・天秤
納期目安 (メーカーに在庫がある場合)13:30までにご注文の場合約3〜7日後出荷(土日祝日を除く)※表示の納期目安はあくまで目安ですのでお約束ではありません。具体的納期は都度お問い合わせください。お取り寄せ品です!ご注文後[商

その他の計測用具
静電気対策に優れた小型デシケーター。型番SCD-2H外寸法(*mm*)400×350×862内寸法(*mm*)381×325×790※写真のシリカゲル皿は付属していません(推奨シリカゲル皿:ステン正方皿(5-178-02))...
この商品で絞り込む

その他の計測用具
よく一緒に購入されている商品三陽金属 0850 草刈スルスルハードタイプ1,247円 エビス 0120-18-5133 【商品説明】【特長】・いろいろな角度・勾配を測れます。・便利な目盛付きです。・カードサイズなので携帯に便利です...
この商品で絞り込む

その他の計測用具
SCD40センサーモジュールは、CO2、温度、湿度を正確に検出する高度な2イン1で、家族にとってより健康的な環境を確保します。 高感度と高速応答時間が特徴のこのセンサーモジュールは、最小限の電力消費で読み取り値を提供し...

その他の計測用具
【アズワン AS ONE】分析・特殊機器 検査用品 微生物検査用品 ●耐乾燥性に優れ、培地表面がひび割れにくいです。 ●アイソレーター及びクリーンルーム対応です。 ●3重包装で、内袋にはガス滅菌用の吊り穴が付いています。 商品の仕様 ●I

その他の計測用具
特長●カードサイズで携帯に便利な多用途用水平器です。●いろんな角度・勾配を測れます。●見やすい角度目盛りです。●水平・勾配・0〜45度の測定が可能です。用途●多用途用水平器。材質/仕上●アクリル樹脂。仕様●感度:1.00mm/m=0.05
この商品で絞り込む

その他の計測用具
【アズワン AS ONE】分析・特殊機器 培養機器・容器 培地等 ●使いやすく信頼性の高い培地及び洗浄液で正確な無菌試験が可能です 商品の仕様 ●容量、mL:100 ●アプリケーション:無菌試験 ●テストの種類:無菌試験 ●テスト数/...

その他の計測用具
ギフトサービスについて【メール便(クリックポスト)の配送について】※こちらの商品は、30個まで[メール便(クリックポスト)]での発送が可能です。※[メール便]での発送をご希望の場合は、注文確認画面にて[配送方法]を[メール便]に変更
この商品で絞り込む

測量用品
《仕様》 ●表示:8桁 ●出力:0-10VDC,RS232C ●外装材質:アルミニウム ●本体寸法:180×85×34 ●本体重量:約300g ●こちらの商品は、通常納期60日間です。予めご了承下さいませ。

その他の計測用具
【用途】多用途用水平器。【機能・特徴】いろんな角度・勾配を測れます。見やすい角度目盛りです。水平・勾配・0〜45度の測定が可能です。【仕様】●感度:1.00mm/m=0.0573度。●精度:±17.5mm/m=±1.0度以内。●本体カ...
この商品で絞り込む
その他の計測用具カテゴリで検索されているキーワード:
お探しの商品はみつかりましたか?
検索条件の変更
ご利用前にお読み下さい
- ※ ご購入の前には必ずショップで最新情報をご確認下さい
- ※ 「掲載情報のご利用にあたって」を必ずご確認ください
- ※ 掲載している価格やスペック・付属品・画像など全ての情報は、万全の保証をいたしかねます。あらかじめご了承ください。
- ※ 各ショップの価格や在庫状況は常に変動しています。購入を検討する場合は、最新の情報を必ずご確認下さい。
- ※ ご購入の前には必ずショップのWebサイトで価格・利用規定等をご確認下さい。
- ※ 掲載しているスペック情報は万全な保証をいたしかねます。実際に購入を検討する場合は、必ず各メーカーへご確認ください。
- ※ ご購入の前にネット通販の注意点をご一読ください。
- ※ 本ページでは掲載するECサイトやメーカー等から購入実績などに基づいて手数料を受領しています。
- SCD
- DIY・工具
- 計測用具の通販情報・価格比較
- 価格.com
© Kakaku.com, Inc. All Rights Reserved. 無断転載禁止
